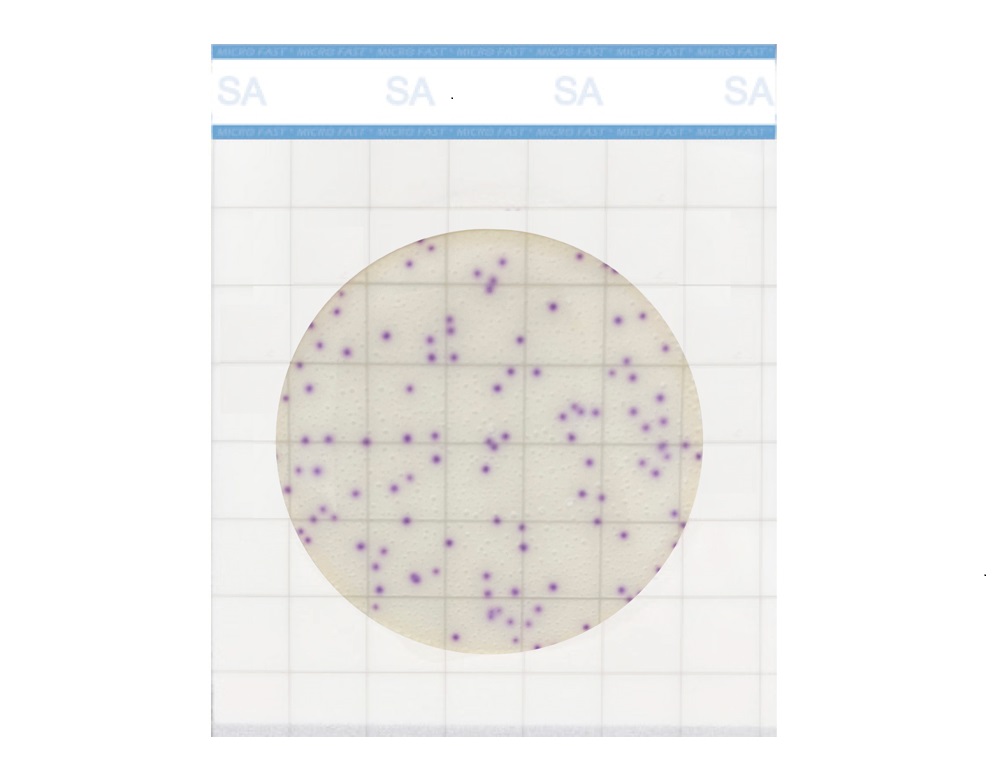
Premium系列金黃色葡萄球菌測試片

Premium系列菌落總數測試片產品介紹
MicroFast?Premium系列菌落總數(Aerobic Count,簡稱 AC)測試片為預制型培養基系統,適合于各類食品、食品原料及生產環境中菌落總數的測定。
樣品處理:同GB方法? ? ? ? ? ? ? ? ? ? ? ? ? 接?種?量:1mL/片
培養溫度:36±1℃*? ? ? ? ? ? ? ? ? ? ? ? ? ? 培養時間:24~48h*
結果判讀:計數紅色菌落? ? ? ? ? ? ? ? ? ? 儲存條件:2-8℃避光冷藏
保?質?期:18個月
培養時間和溫度因方法及樣品而有所不同,水產品培養條件為30±1℃培養48~72h
Premium系列菌落總數測試片儲藏
未開封時,保藏溫度為2~8℃,并在保質期內用完。在濕度較高的環境中,請先將測試片恢復至室溫后開封。開封后,如未用完,需要將測試片放回袋中,鋁箔袋二次折疊后用膠布黏上或封口夾封口,避光保存(不可冷藏),并于一個月之內用完。運輸或短期保存時,將測試片置于常溫即可。
Premium系列菌落總數測試片樣品前處理
參照GB 4789.2-2022,固體和半固體樣品稱取25g放入含有225 mL無菌磷酸鹽緩沖液(或無菌生理鹽水)的無菌均質杯或均質袋內,均質后,制成1:10樣品勻液;液體樣品稱取25mL(當結果要求為每g樣品中菌落總數時,稱取25g)放入含有225 mL無菌磷酸鹽緩沖液(或無菌生理鹽水)的無菌均質杯或均質袋內,均質后,制成1:10樣品勻液。
吸取1:10樣品勻液1mL,注入含有9mL稀釋液的試管內,混勻后成為1:100的樣品勻液,以此類推,制備10倍系列稀釋樣品勻液,每稀釋一次,換用1次1mL無菌吸管或吸頭。
根據樣品的衛生狀況選擇2~3個適宜的稀釋度進行接種檢測(液體樣品也可包括原液)。
規則的環境表面,或樣品表面,可使用采樣棒進行采樣,放入采樣管中擺動混勻后作為樣品勻液,再根據樣品的衛生狀況選擇適宜的稀釋度進行接種檢測;也可使用潤濕后的測試片直接進行采樣。
Premium系列菌落總數測試片操作方法

培養條件因方法及樣品而有所不同,水產品培養條件為30±1℃培養48~72h,其他樣品培養條件為36±1℃培養24~48h。
?
Premium系列菌落總數測試片結果判定
培養后,細菌在測試片上生長后會顯示紅色菌落。可目視或用標準菌落計數器或其它的照明放大鏡計數。建議計數范圍30-300CFU。

魯公網安備37110202000421號
魯公網安備37110202000421號